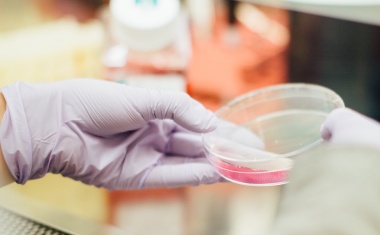
Photo

From Isolation to Insight: Fluorescence Imaging of EVs in Liquid Biopsy Workflows
This infographic hopes to provide scientists with a comprehensive overview of fluorescence imaging strategies for extracellular vesicle research.

This infographic hopes to provide scientists with a comprehensive overview of fluorescence imaging strategies for extracellular vesicle research.

Johnson & Johnson is acquiring clinical-stage biotech Halda Therapeutics for $3.05 billion to enhance its oncology pipeline.

Bayer and Kumquat Biosciences announced today that they have entered into an exclusive worldwide license and collaboration to develop and commercialize Kumquat's KRAS-G12D inhibitor.

Chinese biopharmaceutical company Innovent Biologics announced a collaboration and exclusive license agreement with Roche to advance the development of IBI3009, a novel DLL3-targeted antibody-drug conjugate (ADC) candidate.

Ipsen and Marengo Therapeutics Inc, a clinical-stage biotech company, announced today the expansion of their ongoing oncology research partnership, to include TriStar, Marengo’s next-generation, precision T cell engager (TCE) technology.

Quantro Therapeutics, which focuses on transcription factors targeting cancer treatments, announced that it has reached a key milestone in its joint R&D program with Boehringer Ingelheim.

AstraZeneca has agreed to acquire Fusion Pharmaceuticals, a clinical-stage biopharmaceutical company developing next-generation radioconjugates (RCs).

mRNA-based vaccines against the coronavirus have become firmly established in medicine since the pandemic. Nevertheless, the technology is still at the beginning of its potential. Experts see a wide range of potential applications for this relatively new technology, particularly in infectious diseases and cancer.

Epsilogen and Lonza have successfully completed the manufacturing of a potential cancer treatment. The complex process, which took less than ten months, was carried out at Lonza’s UK site following Good Manufacturing Practice (GMP) standards.

US vaccine maker Moderna and German biotechnology company Immatics agreed on a broad multi-platform research and development collaboration for novel cancer therapies, combining Immatics’ TCR platform with Moderna’s mRNA technology. The project spans various therapeutic modalities including bispecifics, cell therapy and cancer vaccines.

With their triumphant advance, biosimilars are also setting in motion the usual market mechanisms. Biopharma interest groups warn against the automatic substitution of originator drugs.

Gilead Sciences and Tentarix Biotherapeutics established three multi-year collaborations using Tentarix’s proprietary Tentacles platform to discover and develop multi-functional, conditional protein therapeutics for oncology and inflammatory diseases.

Bayer and UK biotech Bicycle Therapeutics have agreed to collaborate to develop and commercialize the latter’s radioconjugates for multiple oncology targets.

German biotech and Covid vaccine maker BioNTech has sealed a major deal with Chinese biotech DualityBio to co-develop and commercialize two cancer antibody drug candidates (ADCs).

Seeking to clear billions of dollars worth of litigation claiming that its iconic baby powder causes cancer, Johnson & Johnson has announced it is now prepared to offer a payout of $8.9 billion over 25 years to resolve all claims.

Pfizer has agreed to acquire Seagen, a global biotech focused on developing cancer treatments, for $43 billion. The announcement comes just a couple of weeks after the Wall Street Journal reported that the two companies were in talks.

US biopharma Sumitovant – a wholly owned subsidiary of Japan’s Sumitomo Pharma – has closed its purchase of the remaining equity in Myovant Sciences, taking full control of the Swiss clinical-stage biopharma for about $1.7 billion. Myovant will now be delisted from the New York Stock Exchange.

Clinical stage biotechs Adaptimmune and TCR2 Therapeutics have agreed to merge, forming what they said would be a “preeminent cell therapy company focused on creating solid tumors” with projected sales of about $27 billion by 2026.

Pfizer is in the early stage of talks to acquire Seagen (formerly Seattle Genetics), a US biotech focused on developing treatments for cancer, according to a report in the Wall Street Journal that cited people familiar with the matter. The purchase price could potentially be more than $30 billion.

US biopharma manufacturing and technology company National Resilience has entered into an agreement with Abu Dhabi investor Mubadala Investment Company to build a manufacturing plant in the United Arab Emirate’s biggest city. This will be the first GMP biopharma facility in the UAE.

AstraZeneca has agreed to acquire Neogene Therapeutics, a clinical-stage biotechnology company focused on the discovery, development and manufacture of next-generation T-cell receptor therapies (TCR-Ts) – a promising and novel cell therapy approach to target cancer.

US drugmaker Merck & Co is going ahead with plans to develop a therapeutic cancer vaccine called mRNA-4157 together with Covid vaccine maker Moderna. This fulfills an agreement first signed in 2016 and amended in 2018.

French biopharma Ipsen and US-based Marengo Therapeutics have formed a strategic partnership that aims to advance two of Marengo’s preclinical immuno-oncology candidates.
UK biopharma Achilles Therapeutics has announced its intention to expand clinical manufacturing capacity in Stevenage, UK, and Pennsylvania, USA.


















